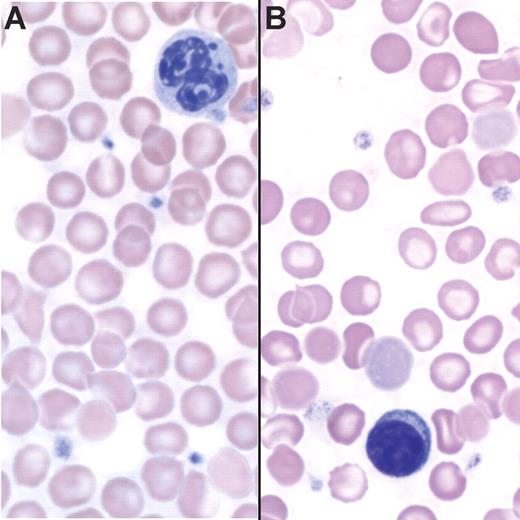
Figure 2. Tg+ mice are anemic. (A) Peripheral blood smear of a Tg− mouse stained with Wright-Giemsa. (B) Peripheral blood smear of a Tg+ mouse stained with Wright-Giemsa showing hypochromia and the presence of target cells.

Abstract
The anemia of inflammation is an acquired disorder affecting patients with a variety of medical conditions, and it is characterized by changes in iron homeostasis and erythropoiesis. Mounting evidence suggests that hepcidin antimicrobial peptide plays a primary role in the pathogenesis of the anemia of inflammation. To evaluate which features of this anemia can be attributed to hepcidin, we have generated mice carrying a tetracycline-regulated hepcidin transgene. Expression of the hepcidin transgene resulted in down-regulation of endogenous hepcidin mRNA. The transgenic mice developed a mild-to-moderate anemia associated with iron deficiency and iron-restricted erythropoiesis. Similar to the anemia of inflammation, iron accumulated in tissue macrophages, whereas a relative paucity of iron was found in the liver. Circulating erythrocytes in transgenic animals had normal survival rates, but transgenic animals had an impaired response to erythropoietin. Thus, hepcidin transgenic mice recapitulate each of the key features of anemia of inflammation in human patients and serve as a useful model of this prevalent disorder.
Introduction
The anemia of inflammation develops in various clinical settings, including infection, inflammatory disorders, malignancies, and trauma.1 Four major features characterize the anemia of inflammation: anemia, decreased serum iron (hypoferremia), sequestration of iron in macrophages, and a blunted response to erythropoietin (Epo). In some cases, red blood cell survival appears to be decreased. Although the anemia of inflammation is frequently described as a mild normocytic, normochromic anemia, it can be severe and can present with microcytic, hypochromic red cells (reviewed in Cartwright2 ). Hypoferremia associated with stainable iron in bone marrow macrophages indicates a perturbation of systemic iron handling.3,4 Some clinical studies reported a shortened life span for red blood cells in patients with rheumatoid arthritis with the anemia of inflammation,5,6 but other studies suggest that this is not a consistent finding.7,8 Finally, defects have been described both in responding to an adequate amount of circulating Epo9,10 and in producing amounts of Epo appropriate for the severity of the anemia.11–13
Hypoferremia occurs in patients with the anemia of inflammation despite sufficient macrophage iron stores, indicating a block in macrophage iron recycling and return of iron to the serum. Mounting evidence suggests that the primary mediator of that block is hepcidin antimicrobial peptide (HEPC), a small protein that is produced in the liver. HEPC is a component of the type II acute-phase response induced by the proinflammatory cytokine interleukin-6.14 Hepc expression is also increased in response to iron loading15 and decreased in response to anemia or hypoxia.16 Cell surface ferroportin (FPN), expressed in macrophages, hepatocytes, and enterocytes, acts as an HEPC receptor.17 FPN is the only known iron exporter in mammalian cells.18 HEPC binding targets FPN to lysosomes for degradation.17 Without FPN at the surface of macrophages, iron transport to the serum slows, causing accumulation of iron within the cells. Similarly, when FPN is removed from the basolateral surface of enterocytes, transfer of dietary iron to the serum is diminished, and retained intracellular iron is lost through exfoliation of the intestinal epithelium (reviewed in Donovan et al19 ). Although these effects of HEPC on iron balance readily explain hypoferremia and macrophage iron sequestration in the anemia of inflammation, roles for Hepc in red blood cell survival, Epo production, and Epo responsiveness in vivo have not been investigated until now.
Transgenic mice expressing mouse Hepc1 cDNA under the control of the liver-specific transthyretin promoter develop severe iron deficiency and anemia,20 whereas transgenic mice expressing Hepc2 have no phenotype.21 Those Hepc1 transgenic mice that survive past birth require injections with iron dextran to ensure their survival, making a complete assessment of their systemic iron handling impossible. A second mouse model of chronic HEPC expression from hepatoma xenografts engineered to express human HEPC was complicated by an anemia specific to the tumors alone.22 Here, we describe the generation of a tetracycline-regulated Hepc1 transgenic mouse that exhibits mild-to-moderate anemia. To assess whether this mouse model faithfully reproduces all of the features of the anemia of inflammation, we have investigated the impact of Hepc1 overexpression on red blood cell production, iron balance in the whole animal, red blood cell survival, Epo production, and Epo responsiveness. We conclude that Hepc1 overexpression slows dietary iron absorption and cycling through macrophages, resulting in iron-restricted erythropoiesis and a failure to respond to adequate Epo levels.
Materials and methods
Generation of tetracycline regulatory element (TRE)–Hepc 1 transgenic mice
A 1.6-kb (kilobase) fragment of Hepc1 was amplified from tail DNA isolated from a 129 S6/SvEv Tac mouse using the forward primer 5′-TCCTTAGACTGCACAGCAGAA-3′ and the reverse primer 5′-GGGGAGGGCAGGAATAAATA-3′. The product was gel-purified and subcloned into the pCR2.1 TA cloning vector (Invitrogen, Carlsbad, CA). The fragment was then excised using BamHI and NotI restriction sites and subcloned into the corresponding sites in pTRE2hyg (Clontech, Mountain View, CA). QuikChange (Stratagene, La Jolla, CA) site-directed mutagenesis was used to add an XhoI site after the β-globin poly-A signal using the primers 5′-CCCTCTTCTCTTATGAACTCGACTCGAGTAATGAATCGGCC-3′ and 5′-GGCCGATTCATTACTCGAGTCGAGTTCATAAGAGAAGAGGG-3′. DNA sequence analysis confirmed the correct sequence of the construct. The excised XhoI transgene fragment (TRE.Hepc1) was then purified from vector sequences using the Geneclean kit (Bio101, La Jolla, CA) and microinjected into FVB oocyte pronuclei by the laboratory of Dr Arlene Sharpe (Brigham and Women's Hospital, Harvard Medical School, Boston, MA) to create the TRE.Hepc1 transgenic line. These mice have no phenotype because the TRE.Hepc1 construct is silent in the absence of the tetracycline transactivator, tTA.
Generation of double transgenic mice
Hemizygous progeny of 1 of the 4 TRE.Hepc1 transgenic founders (no. 2181) were paired with homozygous TgN(tTALAP)5Uh mice kindly provided by the laboratory of Dr Francis Chisari (The Scripps Research Institute) at the discretion of Dr Hermann Bujard (Zentrum für Molekulare Biologie der Universität Heidelberg). These mice have been described previously.23 They carry the tTA transgene under the control of the liver activated CCAAT/enhancer binding protein β promoter. All mice described in this study were females born of TRE.Hepc1 by TgN(tTALAP)5Uh crosses. Their genetic background is composed of C57Bl/6, FVB, and Balb/c inbred strains as well as the NMRI outbred strain. All of the mice derived from these crosses inherited one copy of the tTA transgene. Approximately half also inherited the TRE.Hepc1 transgene. Mice with only the tTA transgene that do not carry or express the TRE.Hepc1 transgene will be denoted “Tg−.” Mice carrying both the tTA and the TRE.Hepc1 transgene will be denoted “Tg+” (Figure 1). None of the mice included in these studies or their parents received doxycycline or tetracycline, resulting in the transgene being “on” throughout the course of these studies.
Animal care
All mice described in this study were housed in the barrier facility at the Children's Hospital Boston. Food and water were provided ad libitum. Unless otherwise specified, animals were maintained on the Prolab RMH 3000 diet (PMI Nutrition, Richmond, IN) which contains 380 parts per million (ppm) of iron. Some Tg− and Tg+ mice serving as Epo controls for the phlebotomized Tg− cohort were born to TgN(tTALAP)5Uh mothers on Mouse Helicobacter MD's (Bioserve, Frenchtown, NJ) and then raised on the same diet which contains 390 ppm iron. No significant differences in hemoglobin or Epo values were detected within the Tg− group or within the Tg+ group when mice were raised on the Helicobacter diet as compared with the Tg− group or the Tg+ group on the standard rodent diet. The cohort of iron-deficient Tg− mice described in Table 2 was born to TRE.Hepc1 by TgN(tTALAP)5Uh breeders on the control diet. Then, at 3 weeks, the resulting pups were weaned onto an iron-deficient diet (Harland Teklad TD 80396, Madison, WI), which contains less than 5ppm iron. Attempts to breed mice on the iron-deficient diet failed because the pups were too iron deficient at birth to survive to weaning age. The Institutional Animal Care and Use Committee of the Children's Hospital Boston approved all mouse procedures.
Genotyping of transgenic mice
Genomic DNA was isolated from tail snips using the Puregene DNA isolation kit (Gentra Systems, Minneapolis, MN). Southern blot analysis was used to verify the presence of the TRE.Hepc1 transgene. DNA (10 μg) was digested with either BamH1 or NheI, fractionated on a 0.7% TAE agarose gel, and transferred to Hybond N+ membrane (Amersham Biosciences, Piscataway, NJ). The blot was probed with a 32PdCTP-labeled polymerase chain reaction (PCR) probe generated from exon 1 of Hepc1 using the primers 5′-TCCTTAGACTGCACAGCAGAA-3′ and 5′-TGGAGATAGGTGGTGCTGCTCAGGCTGGC-3′. PCR analysis was used to verify the presence of the tTA transgene using the primers 5′-CGCTGTGGGGCATTTTACTTTAG-3′ and 5′-CATGTCCAGATCGAAATCGTC-3′ according to Jackson Labs (http://jaxmice.jax.org/pub-cgi/protocols/protocols.sh?objtype=protocol&protocol_id=502).
Northern blot analysis
Total RNA was isolated from snap-frozen tissue using the RNA STAT-60 reagent (Leedo Medical Laboratories, Houston, TX). Total RNA (5 μg) was probed for Hepc with a 32P-dCT–labeled PCR probe generated from a mouse Hepc1 EST (NCBI accession W12913) using the primers 5′-TCCTTAGACTGCACAGCAGAA-3′ and 5′-GGGGAGGGCAGGAATAAATA-3′ or for mouse β-actin using a probe prepared by PCR with primers 5′-GTGACGAGGCCCAGAGCAAGAG-3′ and 5′-AGGGGCCGGACTCATCGTACTC-3′.
Blood collection and analysis
Whole blood for complete blood count was collected from the retro-orbital plexus into EDTA-treated microtainer tubes (Becton Dickinson, Franklin Lakes, NJ) from 8-week-old female mice under Avertin (125-240 mg/kg; Sigma, St Louis, MO) anesthesia and analyzed by the Clinical Core Laboratories at the Children's Hospital Boston on an ADVIA 120 analyzer (Bayer, Tarrytown, NY). Blood smears were stained with Wright-Giemsa stain (Fisher Diagnostics, Middletown, VA) according to the manufacturer's directions.
Iron assays
Microtainer serum separator tubes (Becton Dickinson) were used to separate serum from whole blood collected by retro-orbital bleeding of 8-week-old female mice under Avertin anesthesia according to the manufacturer's instructions. Serum was stored at −80°C before analysis. Serum iron values were determined using the Serum Iron/UIBC kit (ThermoDMA, Arlington, TX) according to the manufacturer's instructions. Livers and spleens were isolated from 8-week-old female mice and stored at −20°C before analysis. Tissue nonheme iron concentrations were determined as previously described.24 Bone marrow was recovered from femurs of 8-week-old female mice using a 25-gauge syringe needle to expel it onto glass slides. The marrow was smeared between 2 glass slides and then stained with Prussian blue stain for iron and counterstained with nuclear fast red by the Histology Laboratory of the Department of Pathology at the Brigham and Women's Hospital (Boston, MA).
In vivo biotin labeling and analysis of peripheral blood
Eight-week-old female mice were anesthetized with Avertin. Fifty microliters of 10 g/L NHS-PEO4 biotin (Pierce, Rockford, IL) in 1 × PBS (Gibco/Invitrogen; pH 7.5) was injected into the retro-orbital space to label peripheral blood cells. This procedure was repeated twice for a total of 3 injections in 24 hours, alternating between eyes. At least 4 hours after the final injection, 15 μL whole blood was collected from the retro-orbital plexus under Avertin anesthesia for the time point at day 0. Thereafter, 15 μL whole blood was collected weekly for 5 subsequent weeks. To quantify the percentage of labeled cells, 5 μL whole blood was diluted in 500 μL Hanks Balanced Salt Solution supplemented with calcium and magnesium (Mediatech Cellgro, Herndon, VA) and 1% BSA (Fraction V; Sigma). Cells were stained for at least 30 minutes in 5 μg/mL Alexa-488 strepavidin (Molecular Probes, Eugene, OR), then washed once in HBSS with calcium and magnesium and 1% BSA and passed through a 70-μm filter (BD Falcon, Franklin Lakes, NJ). Samples were run on the fluorescence-activated cell sorting (FACS) Aria flow cytometer (BD Biosciences, San Jose, CA) and analyzed using FlowJo v.6.1.1 software (Tree Star, Ashland, OR). Staining with 1 μg/mL phycoerythrin-labeled anti–Ter-119 antibody (BD Pharmingen, San Diego, CA) confirmed that greater than 99% of peripheral blood cells were of the erythroid lineage (data not shown). Complete blood counts on whole blood collected at the final time point confirmed that Tg+ mice were anemic and that weekly bleeds of 15 μL did not induce reticulocytosis in Tg− or Tg+ mice (data not shown).
Induction of anemia by phlebotomy
Whole blood (500 μL) was collected from the retro-orbital plexus of 8-week-old female Tg− mice under Avertin anesthesia on day 0. An intraperitoneal injection of 500 μL sterile 1 × PBS (Gibco/Invitrogen) was given to replace the blood volume. Prior to humane killing on day 3, whole blood was collected for complete blood counts and serum analysis as described under “Iron assays.” Serum was stored at −80°C before analysis of Epo levels.
Enzyme-linked immunosorbent assay
Enzyme-linked immunosorbent assay (ELISA) for mouse Epo (R&D Systems, Minneapolis, MN) was performed according to the manufacturer's instructions, in duplicate, on serum samples previously frozen at −80°C. The data shown was verified in a second, independent assay in duplicate.
Statistical analysis
For statistical analysis of 2 groups (Table 1), the Student t test was performed in Excel (Microsoft, Redmond, WA). Statistical analysis of 3 groups (Tables 2–3) was performed with SPSS software (version 14.0; SPSS, Chicago, IL). For each variable, groups were compared using analysis of variance (ANOVA) with a post hoc Bonferroni procedure for pairwise comparisons. For Epo levels, an average of 2 values for each mouse was calculated and then groups were compared. All 2-tailed P values less than .05 were considered statistically significant.
Image acquisition and manipulation
Images from Northern and Southern blot films were acquired using Umax Astra 2400S Scanner and Umax Vista scan 3.1 software (Umax, Dallas, TX). The whole image was adjusted for brightness and contrast to match the original film and labeled using Adobe Photoshop CS (Adobe, San Diego, CA) with no further modifications. Images from peripheral blood and bone marrow smears were acquired using the 100 × oil immersion lens on a Nikon Eclipse E600 microscope (Nikon, Garden City, NY) with attached Spot RT Digital Camera from Diagnostic Instruments (Sterling Heights, MI). Images were captured using Spot 4.5 software from Diagnostic Instruments. The whole image was adjusted for brightness and contrast to match the original slide and labeled using Adobe Photoshop CS with no further modifications.
Results
Generation of tetracycline-regulated Hepc1 transgenic mice
To investigate the role of Hepc1 in the adult mouse, we developed a tetracycline-regulated Hepc1 transgenic mouse line. A PCR-generated fragment of Hepc1 was amplified from 129S6/SvEv Tac genomic mouse DNA and subcloned between TRE and a β-globin poly-A tail signal sequence. The resulting TRE.Hepc1 transgene was introduced into mouse oocytes to generate transgenic founders. Southern blot analysis identified 4 transgenic founder pups (Figure 1A).
Generation of liver-specific, tetracycline-regulated Hepc1 transgenic mice. (A) Southern blot analysis identified 4 TRE.Hepc1 founders (no. 2180, 2181, 2183, 2185) among 14 mice. (B) Because expression of the TRE.Hepc1 transgene requires binding of the tTA to the TRE, the TRE.Hepc1 transgene was only expressed in the presence of tTA. (C) Mice homozygous for the hepatocyte-specific tTA transgene (shown in black on the left) were mated to mice hemizygous for the TRE.Hepc1 transgene (shown in white on the right; Tg denoted by a black oval). Neither of the parental strains expressed Hepc1 from the transgene. All progeny (shown in gray) from this cross carried the tTA transgene. Only mice that additionally carried the TRE.Hepc1 transgene (Tg+) could express transgenic Hepc1. (D) Northern blot analysis confirmed expression of TRE.Hepc1 transgene mRNA (Hepc Tg, lanes 5-8) and down-regulation of endogenous Hepc when compared with controls (lanes 1-4).
Generation of liver-specific, tetracycline-regulated Hepc1 transgenic mice. (A) Southern blot analysis identified 4 TRE.Hepc1 founders (no. 2180, 2181, 2183, 2185) among 14 mice. (B) Because expression of the TRE.Hepc1 transgene requires binding of the tTA to the TRE, the TRE.Hepc1 transgene was only expressed in the presence of tTA. (C) Mice homozygous for the hepatocyte-specific tTA transgene (shown in black on the left) were mated to mice hemizygous for the TRE.Hepc1 transgene (shown in white on the right; Tg denoted by a black oval). Neither of the parental strains expressed Hepc1 from the transgene. All progeny (shown in gray) from this cross carried the tTA transgene. Only mice that additionally carried the TRE.Hepc1 transgene (Tg+) could express transgenic Hepc1. (D) Northern blot analysis confirmed expression of TRE.Hepc1 transgene mRNA (Hepc Tg, lanes 5-8) and down-regulation of endogenous Hepc when compared with controls (lanes 1-4).
None of the identified founders were iron deficient because expression of the TRE.Hepc1 transgene requires binding of the tTA to the TRE (Figure 1B). In the absence of tTA, no Hepc1 was expressed from the transgene. Mice hemizygous for the TRE.Hepc1 transgene were mated to mice homozygous for a hepatocyte-specific tTA transgene under the control of the liver-activated CCAAT/enhancer binding protein β promoter. The resulting progeny all carried the tTA transgene, but only progeny that also carried the TRE.Hepc1 transgene could express the TRE.Hepc1 transgene in hepatocytes. This mating scheme (outlined in Figure 1C) circumvented any parental effect of TRE.Hepc1 expression on the resulting progeny because neither parent was capable of expressing the TRE.Hepc1 transgene. Furthermore, this system limited TRE.Hepc1 expression to the hepatocyte, the primary endogenous source of Hepc1. tTA mice that were not capable of expressing the TRE.Hepc1 transgene will be denoted Tg−. tTA and TRE.Hepc1 mice that did express the TRE.Hepc1 transgene will be denoted Tg+.
Figure 1D demonstrates that TRE.Hepc1 mRNA migrated more slowly than endogenous Hepc, because of the presence of the β-globin poly-A tail. Furthermore, expression of TRE.Hepc1 resulted in down-regulation of endogenous Hepc mRNA. Northern blot analysis detected no TRE.Hepc1 expression in the kidney of Tg+ mice, confirming liver-specific expression of the TRE.Hepc1 transgene in the presence of hepatocyte-specific tTA (data not shown).
Tg+ mice are anemic
A complete blood count revealed hypochromic, microcytic anemia in Tg+ mice (Table 1). We observed a small but significant increase in absolute reticulocyte counts in Tg+ animals, and reticulocyte cellular hemoglobin content was lower. These values did not change dramatically between 4 and 16 weeks of age (data not shown). Peripheral blood smears showed hypochromic red blood cells from Tg+ mice with frequent target cells (Figure 2B). These data suggest that iron-restricted erythropoiesis is the underlying cause of the anemia when TRE.Hepc1 is over expressed.
Tg+ mice are anemic. (A) Peripheral blood smear of a Tg− mouse stained with Wright-Giemsa. (B) Peripheral blood smear of a Tg+ mouse stained with Wright-Giemsa showing hypochromia and the presence of target cells.
Tg+ mice are anemic. (A) Peripheral blood smear of a Tg− mouse stained with Wright-Giemsa. (B) Peripheral blood smear of a Tg+ mouse stained with Wright-Giemsa showing hypochromia and the presence of target cells.
Tg+ mice have an altered pattern of tissue iron stores
We determined the concentrations of nonheme iron in the livers of Tg− and Tg+ mice (Table 2). Nonheme iron concentrations were significantly lower in Tg+ livers. Furthermore, they were lower than values measured in Tg− mice maintained on an iron-deficient diet for 5 weeks after weaning. Considering that hepatic iron content mirrors total body iron content, these findings suggest that overexpression of TRE.Hepc1 causes iron deficiency.
To investigate the effect of TRE.Hepc1 overexpression on macrophage iron storage and recycling, we determined the concentration of nonheme-bound iron in the spleen and serum of Tg− and Tg+ mice (Table 2). In contrast to the liver, where nonheme iron is stored in both hepatocytes and macrophages, splenic nonheme iron primarily reflects the capacity of the reticuloendothelial system to store iron derived from senescent red blood cells. Similarly, serum iron concentration reflects the output of iron-recycling activity, balanced by the erythropoietic iron demand. Splenic nonheme iron concentration was similar in Tg− and Tg+ mice but was substantially lower in Tg− mice maintained on an iron-deficient diet (Table 2). Serum iron values were significantly lower in Tg+ mice but were not decreased in Tg− mice maintained on an iron-deficient diet (Table 2).
The hypoferremia of Tg+ mice suggested a block in iron recycling from macrophages, an increase in iron utilization by erythroid precursors, or both. The low reticulocyte hemoglobin content observed in Tg+ mice (Table 1) was consistent with the interpretation that increased hepcidin expression results in a block in the release of recycled iron from macrophages. If the total body iron endowment was similar in Tg− and Tg+ mice, a block in macrophage iron recycling should result in increased splenic iron stores in Tg+ mice. However, increased circulating hepcidin not only interrupts macrophage iron export but also intestinal iron absorption, resulting in relative iron deficiency in Tg+ mice. To normalize for this deficiency in total body iron, the ratio of spleen to liver nonheme iron was determined (Table 2). Although the iron-deficient diet did not change this ratio significantly in Tg− mice from the Tg− controls on the standard diet, overexpression of TRE.Hepc1 substantially increased the tissue spleen to liver nonheme iron ratio in Tg+ mice. From these data, it can be concluded that overexpression of TRE.Hepc1 alters the distribution of iron in spleen and liver, favoring macrophages of the spleen.
Splenic macrophages are largely responsible for turnover of senescent red blood cells. Bone marrow macrophages may have other roles, for example, directly providing iron for growth and differentiation of erythroid precursor cells. To investigate whether iron was present in bone marrow macrophages, marrow cells from the femurs of Tg− and Tg+ mice were stained with Prussian blue to detect iron. Cells containing iron deposits were visible in both Tg− (Figure 3A-B) and Tg+ (Figure 3C-D) mice.
Tg+ mice have stainable iron in the bone marrow. (A-B) Prussian blue stain detected iron in the bone marrow of 2 Tg− mice. (C-D) Prussian blue stain detected iron in the bone marrow of 2 Tg+ mice. Run-to-run variation accounts for differences in the intensity of nuclear fast red counter stain.
Tg+ mice have stainable iron in the bone marrow. (A-B) Prussian blue stain detected iron in the bone marrow of 2 Tg− mice. (C-D) Prussian blue stain detected iron in the bone marrow of 2 Tg+ mice. Run-to-run variation accounts for differences in the intensity of nuclear fast red counter stain.
Red blood cells from Tg+ mice have normal survival rates
The survival rates of peripheral red blood cells were measured by flow cytometry to determine whether the relative accumulation of iron in the spleens of Tg+ mice resulted from accelerated removal of red blood cells from circulation. The results are presented as histogram plots in Figure 4. Unlabeled peripheral blood cells are shown in Figure 4A. At least 90% of peripheral blood cells were biotin-labeled in vivo on day 0 in Tg− and Tg+ mice (Figure 4B). By day 21, 2 distinct populations, representing labeled and unlabeled cells, could be detected by flow cytometry (Figure 4C). We observed no difference in the survival rate of red blood cells in Tg+ mice when compared with Tg− mice (Figure 4D). These data indicate that constitutive expression of TRE.Hepc1 does not lead to increased turnover of circulating erythrocytes.
Red blood cells from Tg+ mice have normal survival rates. (A) Background FITC signal from unstained peripheral blood cells collected from a representative Tg− mouse on day 0. (B) FITC signal from in vivo biotin-conjugated peripheral blood cells of the same mouse stained with Alexa-488 strepavidin on day 0. (C) At day 21, 2 populations (older, biotin-conjugated peripheral blood cells and newer, unstained peripheral blood cells) of peripheral blood cells were identified in the same mouse. (D) The survival of peripheral blood cells from Tg+ mice (n = 3, open circles, average shown in gray circle, solid line) did not differ from that of Tg− mice (n = 4, closed squares, average shown in gray square, dotted line).
Red blood cells from Tg+ mice have normal survival rates. (A) Background FITC signal from unstained peripheral blood cells collected from a representative Tg− mouse on day 0. (B) FITC signal from in vivo biotin-conjugated peripheral blood cells of the same mouse stained with Alexa-488 strepavidin on day 0. (C) At day 21, 2 populations (older, biotin-conjugated peripheral blood cells and newer, unstained peripheral blood cells) of peripheral blood cells were identified in the same mouse. (D) The survival of peripheral blood cells from Tg+ mice (n = 3, open circles, average shown in gray circle, solid line) did not differ from that of Tg− mice (n = 4, closed squares, average shown in gray square, dotted line).
TRE.Hepc1 transgenic mice respond poorly to available Epo
Reticulocyte numbers were only modestly increased in Tg+ mice despite a significant decrease in total hemoglobin concentration (Table 1). To determine whether the relationship between hemoglobin, Epo, and erythropoiesis remained intact in Tg+ mice, we evaluated Epo levels in Tg−, Tg+, and phlebotomized Tg− mice. The phlebotomized group was derived from Tg− mice, which were bled once on day 0 and then humanely killed on day 3. Nine Tg+ mice and 13 phlebotomized Tg− mice with the same average hemoglobin concentration (13 g/dL) were selected for a comparison of serum Epo concentrations (Table 3). Epo levels were significantly increased in Tg+ mice as compared with Tg− mice. Epo levels also tended to be greater in phlebotomized Tg− mice than Tg− mice, but this difference was not significant by ANOVA with a Bonferroni pairwise comparison. The elevated Epo level of Tg+ mice was significantly greater than phlebotomized Tg− mice. These data suggest that the decrease in oxygen tension resulting from a lower hemoglobin level is appropriately sensed in Tg+ mice and that they respond by elevating Epo. Within 3 days, phlebotomized Tg− mice have clearly responded to the decrease in hemoglobin and mild elevation in Epo because the absolute number of reticulocytes increased substantially. In contrast, Tg+ mice did not respond to elevated Epo as they showed only a slight increase in absolute reticulocyte count. From these data, we conclude that overexpression of TRE.Hepc1 results in a blunted response of the bone marrow to adequate Epo levels.
Discussion
The TRE.Hepc1 transgenic mice described here provide a new model for the anemia of inflammation. They show the key features of the anemia of inflammation that are common to multiple patient groups, including anemia, hypoferremia, stainable macrophage iron, and poor responsiveness of erythroid progenitors to available Epo.
Expression of the TRE.Hepc1 transgene in our model decreased endogenous Hepc expression. This is consistent with the regulation of Hepc observed in other Hepc transgenic mouse models20,25 as well as in a unique clinical situation wherein adenomas-producing HEPC was associated with an iron-refractory anemia similar to that seen in the anemia of inflammation.26
The clinical presentation of the anemia of inflammation is variable; red cells can be normocytic and normochromic or microcytic and hypochromic.2 This variability is likely related to differences in iron stores, genetic modifiers of the efficiency of iron absorption and cycling, and the type and duration of the underlying inflammatory condition. Our TRE.Hepc1 transgenic mice have a mild-to-moderate hypochromic, microcytic anemia with decreased reticulocyte cellular hemoglobin. Because these immature erythrocytes are not able to hemoglobinize adequately, we conclude that overexpression of TRE.Hepc1 results in functional iron deficiency for erythroid precursors.
We have demonstrated that overexpression of TRE.Hepc1 resulted in both iron deficiency and sequestration of iron in the spleen. Furthermore, stainable iron was found in the bone marrows of Tg+ mice. We hypothesize that hypoferremia caused by macrophage iron retention and impaired iron absorption prevents adequate delivery of iron to erythroid precursors. In the clinical setting of the anemia of inflammation, HEPC regulation of FPN stability in both enterocytes and macrophages likely explains an anemia that is not responsive to oral iron therapy and poorly responsive to parenteral iron therapy.
The primary iron source for erythroid precursors is serum transferrin.27–29 Therefore, the hypoferremia in Tg+ mice may fully explain the iron-restricted erythropoiesis that we have observed. However, macrophages have long been known to support growth and development of erythroblasts in bone marrow erythroid islands.30 It is not clear whether iron retention in macrophages solely affects iron acquisition of erythroid precursors because macrophages fail to donate iron to transferrin, or whether macrophage iron retention has a more direct effect on the development of erythroblasts in erythroid islands.
The normal survival time of labeled red blood cells that we observed in vivo is consistent with erythrocyte survival studies tracking autologous-labeled red cells transfused into patients with rheumatoid arthritis.2,7,8 However, other studies in similar patient groups suggested that an extracorpuscular mediator of erythrocyte lifespan may contribute to the anemia of inflammation in patients with rheumatoid arthritis. Although the survival time of patient cells in healthy subjects was reported to be normal, the survival time of normal cells in patients with rheumatoid arthritis was slightly shortened.2,5 It has been suggested that the extracorpuscular defect is only “unmasked” with normal cells in patients with rheumatoid arthritis because they have a younger complement of peripheral erythrocytes. The modest increase in reticulocytes in our system may, similarly, mask an extracorpuscular defect. Unfortunately, the mixed genetic background of our system does not allow us to test this possibility. However, it is clear from the survival studies reported here that the relative redistribution of iron to the spleen is not the result of increased turnover of erythrocytes.
Two types of blunted EPO response have been described in patients with the anemia of inflammation. First, erythropoiesis has been shown to be impaired, despite normal to increased EPO levels.31 Second, EPO levels in some patients have been considered inappropriately low for the severity of anemia.32 To evaluate the Epo response in the presence of the TRE.Hepc1 transgene, we compared Tg+ mice to phlebotomized Tg− mice when both sets had hemoglobin concentrations of 13 g/dL. Despite adequate Epo levels, Tg+ mice did not increase reticulocyte production to the same extent as phlebotomized Tg− controls. The decreased reticulocyte hemoglobin content observed in Tg+ mice (Table 1) suggests that Tg+ mice simply lack adequate iron to appropriately increase erythropoietic capacity. However, a recent publication suggests that HEPC might, alternatively, have a direct effect on erythroid precursors.33
A variety of underlying disease processes result in the anemia of inflammation, and some features of the anemia of inflammation may be due to other disease-related factors. HEPC has been directly implicated as a cause of anemia in a cohort of patients with liver adenomas.26 It has been indirectly implicated in anemic patients with ovarian cancer34 through its regulation by interleukin-6.14 Despite the clear association of HEPC and interleukin-6 in the anemia of inflammation, there are probably other unidentified factors involved in the pathogenesis of some cases of the anemia of inflammation. Most studies describing clinical features of the anemia of inflammation have focused on patients with rheumatoid arthritis.35 Tumor necrosis factor α (TNFα) plays an important role in the pathogenesis of the anemia of inflammation.36,37 Transient TNFα treatment of rats38 and mice39 results in hypoferremia, anemia, and increased red blood cell turnover. However, HEPC levels do not increase in response to TNFα,39,40 suggesting that HEPC-independent mechanisms may also contribute to the clinical features of the anemia of inflammation in rheumatoid arthritis.
Our TRE.Hepc1 transgenic mouse model allowed us to investigate the role of Hepc1 independent of inflammation. On the basis of the phenotype of our mice, we conclude that overexpression of Hepc1, alone, can result in anemia indistinguishable from the anemia of inflammation, characterized by sequestration of iron in macrophages, iron-restricted erythropoiesis, and low hemoglobin concentrations. Our observations suggest that manipulation of hepcidin levels may be a useful therapeutic intervention in this common disorder.
Authorship
Contribution: C.N.R. designed the experiments, participated in their execution, analyzed the data, and wrote the manuscript; H.H.M. and I.A. assisted with the execution of the experiments; G.L. provided conceptual and technical expertise for the red blood cell survival experiments; D.Z. performed statistical analysis of the data, N.C.A. guided the overall development of the research plan and contributed to the writing of the manuscript.
Conflict-of-interest disclosure: The authors declare no competing financial interests.
Correspondence: Cindy N. Roy, Karp Family Research Laboratories 08118, 1 Blackfan Ave, Boston, MA 02115; e-mail: croy@enders.tch.harvard.edu.
The publication costs of this article were defrayed in part by page charge payment. Therefore, and solely to indicate this fact, this article is hereby marked “advertisement” in accordance with 18 USC section 1734.
Acknowledgments
We thank Adriana Donovan, Mark Fleming, Hiromi Gunshin, Lina Du, and David Bowman for technical advice as well as Renuka Sastry and the members of the Andrews and Fleming laboratories for helpful discussions.
This work was partially supported by the National Institutes of Health (grant R01 DK053813) (N.C.A) and (grant KO1 DK065635) (C.N.R.), a Roche Foundation for Anemia Research grant (N.C.A), and an award from the Office for Faculty Development of Children's Hospital Boston (C.N.R.).
N.C.A. was an Investigator of the Howard Hughes Medical Institute.